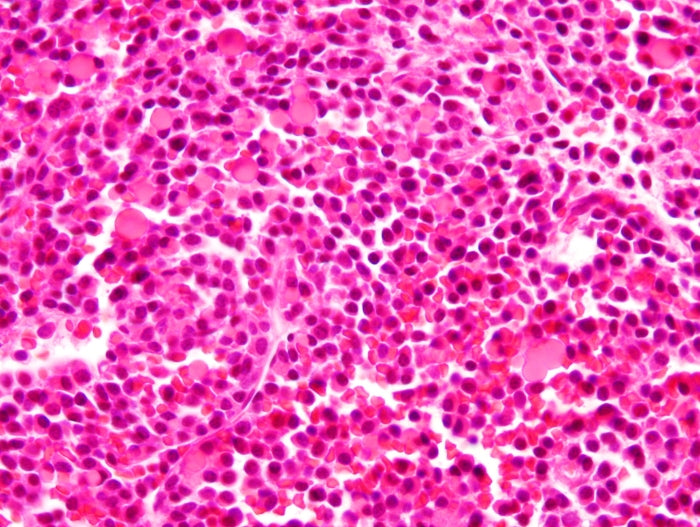

Cell images become jewelry for a cause
We transform cell images, or histology slides, into stunning charity jewelry. By revealing the unexpected beauty within disease, we create pieces that spark hope, spread awareness, and create positive change. Every purchase gives back to fund research or support patients, and moves us closer to cures.
Show your support for Multiple Myeloma Cancer awareness with this charming, yet powerful necklace. You can stay stylish while doing good! Get yours now and join the fight against cancer.
This small round pendant features a hand-cut photo of a Multiple Myeloma Cancer cell encased in resin. The stones on the back of the necklace are faceted round Pink Tourmaline. Choose between a 16-18 inch Sterling Silver or Gold Filled chain or an adjustable 12-24 inch black cord.
For every purchase, 10% of the purchase price is donated to the Multiple Myeloma Research Foundation. We're partnering with them to help find a cure for Multiple Myeloma through their cancer research and clinical trials.
I USED THIS IMAGE TO CREATE THE MAGNIFY MULTIPLE MYELOMA NECKLACE PENDANT. CAN YOU SEE WHICH PART IT CAME FROM?

With 10% of the purchase price from your purchase of this Multiple Myeloma Jewelry going to the Multiple Myeloma Research Foundation (MMRF), you’re helping fund cutting-edge research that is transforming multiple myeloma treatments and patient care. This foundation is committed to accelerating a cure and extending the lives of myeloma patients. Learn more about the Multiple Myeloma Research Foundation here. For more on how we support MMRF, click here.
To keep your jewelry looking like new store it in a dry, enclosed space. A zipper bag is a great way to keep outside air from tarnishing your jewelry.
Always take your jewelry off before going near water, including swimming, showering or even exercising. Make sure to apply all lotions and perfumes before putting on your jewelry.
Take care not to scratch the resin by avoiding sharp objects and rough surfaces. Please remove your jewelry, especially rings, prior to exercising, cleaning, moving or any other activities that may cause your jewelry to become scratched.
Our products are very high quality and guaranteed for life, but they are not indestructible. Please do your part to keep it nice for as long as possible.
For Sterling Silver:
Clean with a dry polishing cloth. Some silver cleaners may be used if a cloth doesn’t work, but always take care not to submerge stones.
For 14k Gold Filled:
Clean with a dry polishing cloth. If a cloth doesn’t work, you can use a mild soap and water combination with a toothbrush to remove tarnish. Take care not to damage any stones.
For Cords:
To clean, gently scrub the cord with a soft toothbrush and diluted Dawn dish soap, rinse with cold water, and dry completely—avoid soaking pendants or nylon cords.
For more detailed instructions read our full jewelry care article here.
Necklace Length Guide:

Tips for finding your perfect length necklace:
1. Find a piece of string and lay it around your neck to where you'd like the necklace to lay.
2. Cut the string. You may want assistance doing this so you don't cut your hair! Or you can do it in front of your body.
3. Lay the string out flat and measure it with a ruler in inches.
4. Now you have the necklace length that's perfect for you!
Each piece is handmade to order and ships within 1-5 business days (typically 2-3). If you need something quickly or are concerned about turn around time, contact us & we'll be happy to help.
Orders ship from Los Angeles, CA, via USPS or UPS with tracking. U.S. orders over $150 ship free, while shipping for smaller orders is usually around $5. Taxes are applied at checkout based on your state.
Hassle Free Returns and Exchanges on US orders within 30 days. We'll provide a return shipping label for you, just contact us at 310.844.1958 or info@ReviveJewelry.com if you'd like to return or exchange an item.
Need more details? Visit our FAQ page or contact us at info@ReviveJewelry.com.
What materials are used, and is the jewelry safe for sensitive skin?
Our jewelry is made using high-quality materials including sterling silver and gold-filled components. All pieces are nickel-free and designed to be gentle on sensitive skin.
Our cord styles use durable, high-quality nylon cord, and our pendants are crafted with jeweler's grade resin for clarity and longevity. We carefully select materials that are both comfortable for everyday wear and made to last.
How long will my order take to ship?
Orders typically ship within 1–5 business days, with most shipping in 1–3 business days.
Custom pieces require additional time and typically ship within 7–10 business days due to the extra care and craftsmanship involved.
If you need your order sooner, feel free to reach out. While we can’t guarantee rush requests, we’re always happy to help whenever possible.
Can I customize this piece for a different cause or meaning?
Yes, we’re always happy to create something meaningful to you. Many of our designs can be customized to represent a specific cause, journey, or personal story.
If you don’t see what you’re looking for, feel free to reach out. We’d love to bring your vision to life. You can contact us at info@revivejewelry.com, call or text us at (310) 844-1958, or visit our Contact Us page.
How is this piece made?
Each piece is designed with intention and then carefully handmade. Our resin pendants are created using imagery inspired by histological images of the cancer or disease each piece represents. We use publicly available scientific microscope images of cells and transform them into something beautiful and full of hope.
Because each piece is handmade, slight variations may occur. We always do our best to match the product images as closely as possible, while ensuring every piece reflects the same overall look and feel. Each one is a small, meaningful work of art made with care.
Does every purchase give back?
Yes. 10% of the purchase price is donated to support cancer and disease research and partner organizations. Every piece is designed to not only hold meaning, but to help make a difference.